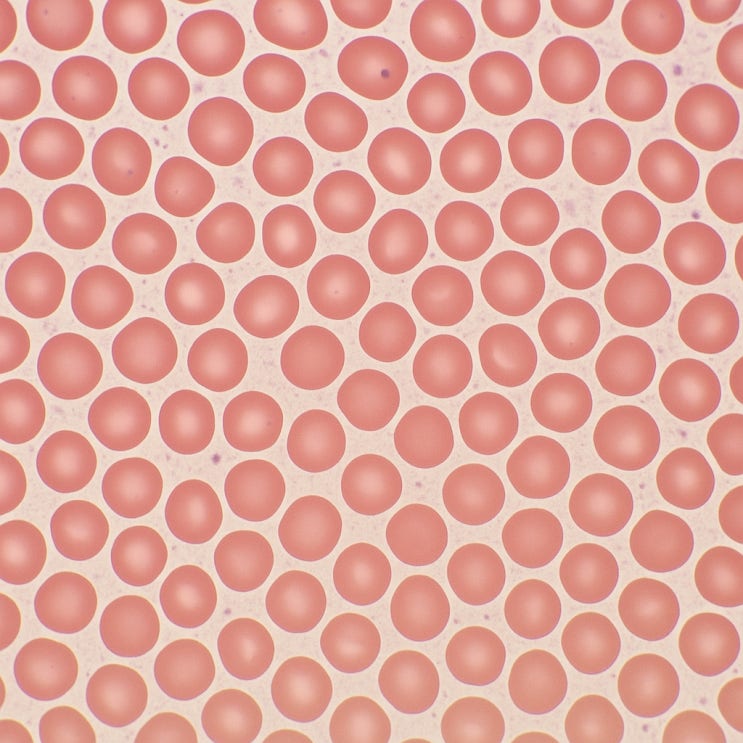

“목에 혹이 만져지나요? 갑상선 결절·물혹 원인과 관리법”
2025.09.07

건강검진에서 '갑상선 결절' 혹은 '물혹'이 있다는 얘기를 들으면 누구나 당황할 수 ...
출처
https://blog.naver.com/milee0822/223961600313
이슈모어 핫이슈
-
 100일의 거짓말, D-100 티저 공개…김유정·박진영 첩보 로맨스 베일 벗었다
100일의 거짓말이 첫 티저 영상을 공개하며 방송 100일 전 카운트다운을 시작했다. tvN 새 토일드라마 …
100일의 거짓말, D-100 티저 공개…김유정·박진영 첩보 로맨스 베일 벗었다
100일의 거짓말이 첫 티저 영상을 공개하며 방송 100일 전 카운트다운을 시작했다. tvN 새 토일드라마 …
-
 채수빈, SBS 꽃은 미끼야 출연 확정…9년 만에 안방극장 새 변신
채수빈 꽃은 미끼야 출연 소식이 전해지며 배우 채수빈의 차기 행보에 관심이 쏠리고 있다. 채수빈은 SBS 새…
채수빈, SBS 꽃은 미끼야 출연 확정…9년 만에 안방극장 새 변신
채수빈 꽃은 미끼야 출연 소식이 전해지며 배우 채수빈의 차기 행보에 관심이 쏠리고 있다. 채수빈은 SBS 새…
-
 판빙빙 부천영화제 참석 이후 다시 집중된 관심…대륙의 여신 존재감 입증
판빙빙 부천영화제 참석 소식이 전해지며 국내 영화 팬들의 관심이 다시 집중되고 있다. 중국을 대표하는 배우 …
판빙빙 부천영화제 참석 이후 다시 집중된 관심…대륙의 여신 존재감 입증
판빙빙 부천영화제 참석 소식이 전해지며 국내 영화 팬들의 관심이 다시 집중되고 있다. 중국을 대표하는 배우 …
관련 포스팅
Copyright blog.dowoo.me All right reserved.